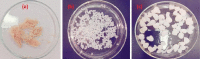

Chitosan-Based Architectures as an Effective Approach for the Removal of Some Toxic Species from Aqueous Media
- PMID: 36969416
- PMCID: PMC10035021
- DOI: 10.1021/acsomega.2c07264
Chitosan-Based Architectures as an Effective Approach for the Removal of Some Toxic Species from Aqueous Media
Abstract
Modified uncrosslinked and crosslinked chitosan derivatives were investigated as green sorbents for the removal of copper (Cu2+) and lead (Pb2+) cations from simulated solutions. In this regard, N, O carboxymethyl chitosan (N, O CMC), chitosan beads (Cs-g-GA), chitosan crosslinked with glutaraldehyde/methylene bisacrylamide (Cs/GA/MBA), and chitosan crosslinked with GA/epichlorohydrin (Cs/GA/ECH) were prepared and characterized by Fourier transform infrared spectroscopy, X-ray diffraction, thermogravimetric analysis, and scanning electron microscopy analyses. Atomic force microscopy investigation was carried out to compare the surface topography of the prepared samples before and after the metal uptake. The kinetics of the removal process were investigated by pseudo-first-order and -second-order models. Moreover, the adsorption isotherms were carefully studied by applying Langmuir and Freundlich models. The data reveal that upon adsorption of copper(II) metal ions, all chitosan-modified products followed the Langmuir isotherm except for Cs/GA/ECH which followed the Freundlich isotherms, and the highest adsorption capacity (q e) was obtained for Cs/GA/MBA due to the formation of stable chelate structures between the metal cation and the functional groups present on the modified chitosan product. The order of metal uptake at the optimum pH value is as follows: Cs/GA/MBA (Cu: 95.7 mg/g, Pb: 99.15 mg/g), Cs/GA/ECH (Cu: 80.4 mg/g, Pb: 93.14 mg/g), Cs-g-GA (Cu: 77 mg/g, Pb: 88.4 mg/g), and N, O CMCh (Cu: 30.2 mg/g, Pb: 44.8 mg/g). The AFM data confirmed the metal uptake process by comparing the roughness and height measurements of the free sorbents and the metal-loaded sorbents.
© 2023 The Authors. Published by American Chemical Society.
Conflict of interest statement
The authors declare no competing financial interest.
Figures

References
-
- Abdel-Raouf M. E.; Maysour N. E.; Abdul-Raheim A. M.; El-Saeed S. M.; Farag R. K. Synthesis and Study of the Surface Properties of Alkylnaphthalene and Alkylphenanthrene Sulfonates. J. Surfactants Deterg. 2011, 14, 23–30. 10.1007/s11743-010-1197-4. - DOI
-
- Atta A. M.; Abdel-Raouf M. E.; Abdul-Raheim A. M.; Abdel-azim A. A. Water Based Surfactants from Recycled Poly (ethylene terephthalate) Waste: their use as beach cleaners and in Petroleum Sludge Recovery. Prog. Rubber, Plast. Recycl. Technol. 2004, 20, 311.
-
- Abdel-Raouf M. E. Biodegradable polyoxyethylenated pentaerythritol quadric esters as oil spill dispersants. Tenside, Surfactants, Deterg. 2012, 49, 114–123. 10.3139/113.110172. - DOI
-
- Poudel M. B.; Awasthi G. P.; Kim H. J. Novel Insight into the Adsorption of Cr(VI) and Pb(II) Ions by MOF Derived Co-Al Layered Double Hydroxide @hematite Nanorods on 3D Porous Carbon Nanofiber Network. Chem. Eng. J. 2021, 417, 129312.10.1016/j.cej.2021.129312. - DOI
LinkOut - more resources
Full Text Sources
Miscellaneous